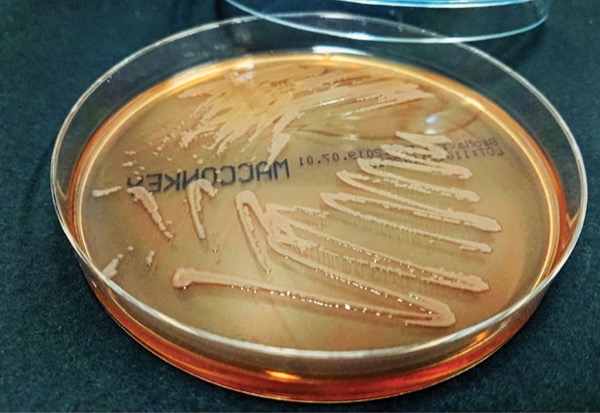
image

The Infectious Diseases Society of America (IDSA) recently updated guidance for the treatment of antimicrobial-resistant gram-negative infections (bit.ly/3WJoscE-idse).
The guidance updated recommendations for treating infections caused by extended-spectrum beta-lactamase–producing Enterobacterales (ESBL-E), AmpC beta-lactamase–producing Enterobacterales, carbapenem-resistant Enterobacterales (CRE), Pseudomonas aeruginosa with difficult-to-treat resistance (DTR), carbapenem-resistant Acinetobacter baumannii (CRAB) and Stenotrophomonas maltophilia. Each of these pathogens cause a range of health-system associated infections and carry significant morbidity and mortality, according to the guidelines.
Some significant changes include:
- Sulbactam-durlobactam (sul-dur; Xacduro, Innoviva Specialty Therapeutics), approved in 2023, is now the preferred agent to treat CRAB infections, in combination with meropenem or imipenem-cilastatin. High-dose ampicillin-sulbactam with at least one other agent has been changed from a preferred to an alternative regimen if sul-dur is not available.
- For S. maltophilia, the guidance recommends one of two paths: either a combination of two agents from the following list in order of preference—cefiderocol (Fetroja, Shionogi), minocycline, trimethoprim-sulfamethoxazole or levofloxacin—or the combo of ceftazidime-avibactam (Avycaz, Allergan) plus aztreonam. Tigecycline has been removed as a component of combination therapy.
- For ESBL-E, the guidance notes that re-review of available and newer data indicates that ceftolozane-tazobactam (C/T; Zerbaxa, Merck) is likely to be effective; however, it suggests that this agent be preserved for the treatment of DTR P. aeruginosa or polymicrobial infections (e.g., DTR P. aeruginosa and ESBL-E).
Several studies saw similar results between C/T and meropenem, according to the panel. In an analysis of a subset of patients in a randomized trial, 72 with ESBL-E intraabdominal infections experienced a similar clinical cure as meropenem (J Antimicrob Chemother 2017;72[1]:268-272). Another trial comparing ESBL-E pneumonia patients also found C/T noninferior to meropenem: 21% taking C/T and 29% taking meropenem had similar 28-day mortality, as well as clinical cure and microbiological eradication rates (Lancet Infect Dis 2019;19[12]:1299-1311).
As far as treating CRAB infections, the recommendations cite the need for multiple agents.
“For moderate to severe CRAB, combination therapy with at least two active agents is advised wherever possible, even if a single agent has demonstrated activity, until clinical improvement,” said guidance co-author Emily Heil, PharmD, MS, a professor in the Department of Practice, Sciences and Health Outcomes Research at the University of Maryland School of Pharmacy and the coordinator of the antimicrobial stewardship program at the University of Maryland Medical Center, in Baltimore. She noted that sul-dur is truly “built for CRAB. I know it’s expensive. I know as stewards we’re dying inside, but it’s the first drug we’ve had with a real randomized clinical trial that shows promise.”
At a session at MAD-ID 2024, Dr. Heil explained that unlike other traditional beta-lactamase inhibitors, sulbactam has intrinsic activity against A. baumannii because in high doses it saturates selected penicillin-binding proteins. “It is not interchangeable with any of the other beta-lactamase inhibitors,” she stressed. “This is not the time to make a change to a PO [oral] regimen; sulbactam is unique in its role here, retaining activity against some strains that produce OXA carbapenemases, a common source of resistance for CRAB.”
For S. maltophilia—a pathogen that poses management challenges similar to CRAB in that it is often unclear whether it represents colonization or a genuine infection—there were not many good options, Dr. Heil said. “This is a tricky organism that loves to make biofilm and has a great deal of intrinsic resistance.”
The new guidance notes that a “standard-of-care” antibiotic regimen for S. maltophilia infections is lacking, as are clinical trials comparing the effectiveness of commonly used agents for S. maltophilia. It positions cefiderocol as a preferred component of combination therapy, at least until clinical improvement is observed. But the data on the recommended combinations are far from clear-cut. “We don’t necessarily have data saying that combinations lead to better outcomes than monotherapy,” she acknowledged.
Warren Rose, PharmD, MPH, an associate professor of pharmacy and medicine at the University of Wisconsin, in Milwaukee, offered updates on therapeutic challenges with gram-positive bacteria. “While these bacteria may have lower resistance than organisms like CRAB and Stenotrophomonas, they can be hard to get rid of, seeming like they are susceptible to antibiotics but still able to subvert response,” he said.
He focused primarily on Staphylococcus aureus and enterococcal complex infections, noting that bloodstream infections represent the major needs and challenges. “Gram-positive staphis a major burden in terms of having more than one resistance potential leading to mortality. S. aureus is the pathogen with the highest associated MDR [multidrug-resistant]–attributable mortality, while the Enterococcus burden is less common, but treatment options are limited, with few options even in development.”
On the bright side, the FDA approved a new agent against S. aureus, ceftobiprole (Zevtera, Basilea Pharmaceutica International), in April for right-sided infectious endocarditis, bacteremia and skin and soft tissue infections. “It’s been approved in the EU [European Union] for more than a decade, and they have a lot of experience with its use in complicated infections.”
But he noted that in the ERADICATE trial that led to its approval, most patients had skin and soft tissue infections; only 25% had methicillin-resistant S. aureus, and 8% had persistent bacteremia (N Engl J Med 2023;389:1390-1401). “The dose and infusion [500 mg IV every six hours for eight days and every eight hours thereafter] are also fairly unconventional compared to what we have now with ceftaroline [typically 600 mg IV every 12 hours].”
In the realm of long-acting agents, Dr. Rose predicted that the ongoing DOTS study of dalbavancin as an option for treating S. aureus bacteremia will prove to be groundbreaking. “They are using the new desirability of outcome (DOOR) ranking, based on a number of factors including mortality, to determine if dalbavancin is noninferior to standard of care,” he said (Trials 2022;23[1]:407). He also pointed to multiple studies suggesting that multidose oritavancin may be a useful sequential therapy for gram-positive bacteremia (Antibiotics [Basel] 2023;12[10]:1498; Int J Antimicrob Agents 2024;63[6]:107165).
He outlined priorities for future studies. “These should include life measurement in these patients, incorporating patient experiences and the impact of these infections on multiple domains of health-related quality of life; biomarker development for infection progression, resolution and risk stratification; and management approaches for initial therapy, persistent infection and oral step-down optimization,” he said.
Dr. Rose reported relationships with Basilea Pharmaceutica, Ferring Pharmaceuticals, Melinta Therapeutics, Merck, Paratek and Pfizer. Dr. Heil reported no relevant financial disclosures.
This article is from the August 2024 print issue.